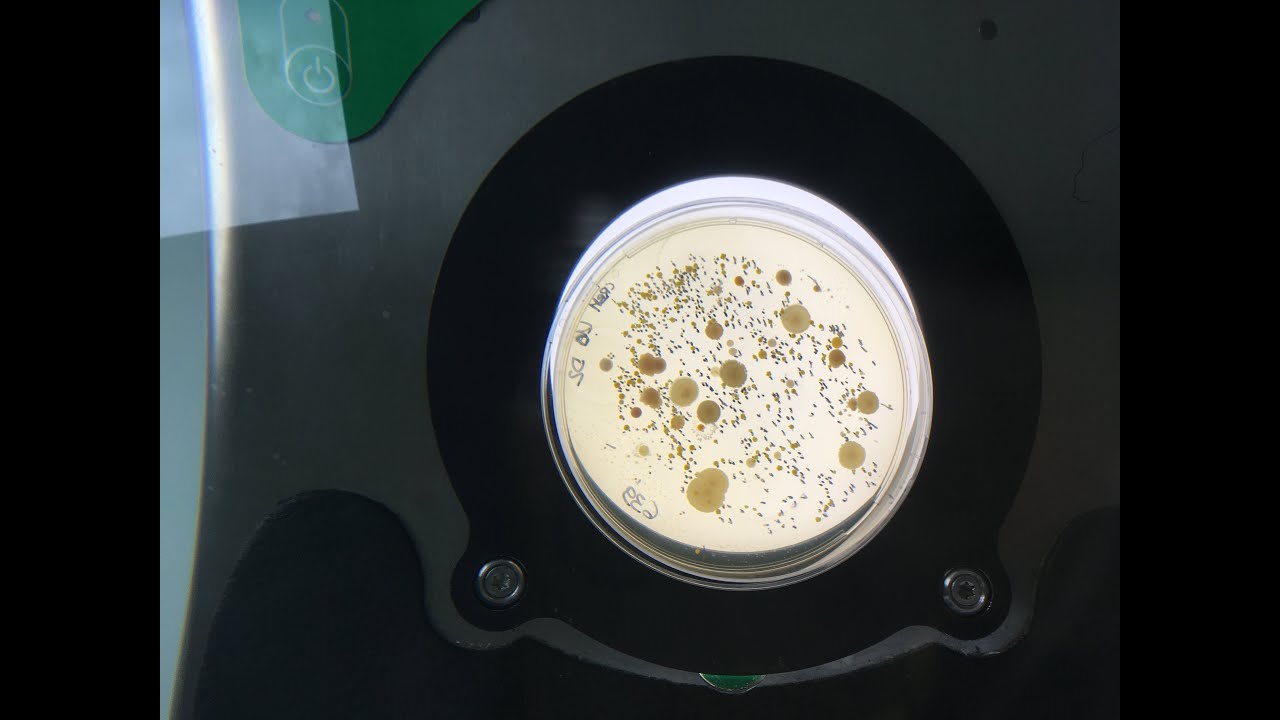
L'Unité Mixte de Recherche  sur le Fromage d'Aurillac: un labo dédié aux bactéries du lait

L'Unité Mixte de Recherche sur le Fromage d'Aurillac: un labo dédié aux bactéries du lait
Автор: France 3 Auvergne-Rhône-Alpes
Загружено: 2020-01-16
Просмотров: 994
Pour mieux connaître les bactéries du lait et leurs actions sur la fabrication du fromage, l'Unité Mixte de Recherche sur le Fromage d'Aurillac dans le Cantal les étudies depuis plus de 40 ans. Ce laboratoire s'interroge aussi sur les conditions de conservation des fromages et les questions de santé alimentaire.
Plus d'infos ici►https://france3-regions.francetvinfo....
Retrouvez-nous sur :
Notre site web
http://france3-regions.francetvinfo.f...
Nos pages Facebook
/ f3alpes
/ france3auvergne
/ france3rhonealpes
Nos comptes Twitter
/ f3alpes
/ f3auvergne
/ f3rhone_alpes
Sur Instagram
/ france3alpes
/ france3auvergne
/ france3rhonealpes
Доступные форматы для скачивания:
Скачать видео mp4
-
Информация по загрузке:



















